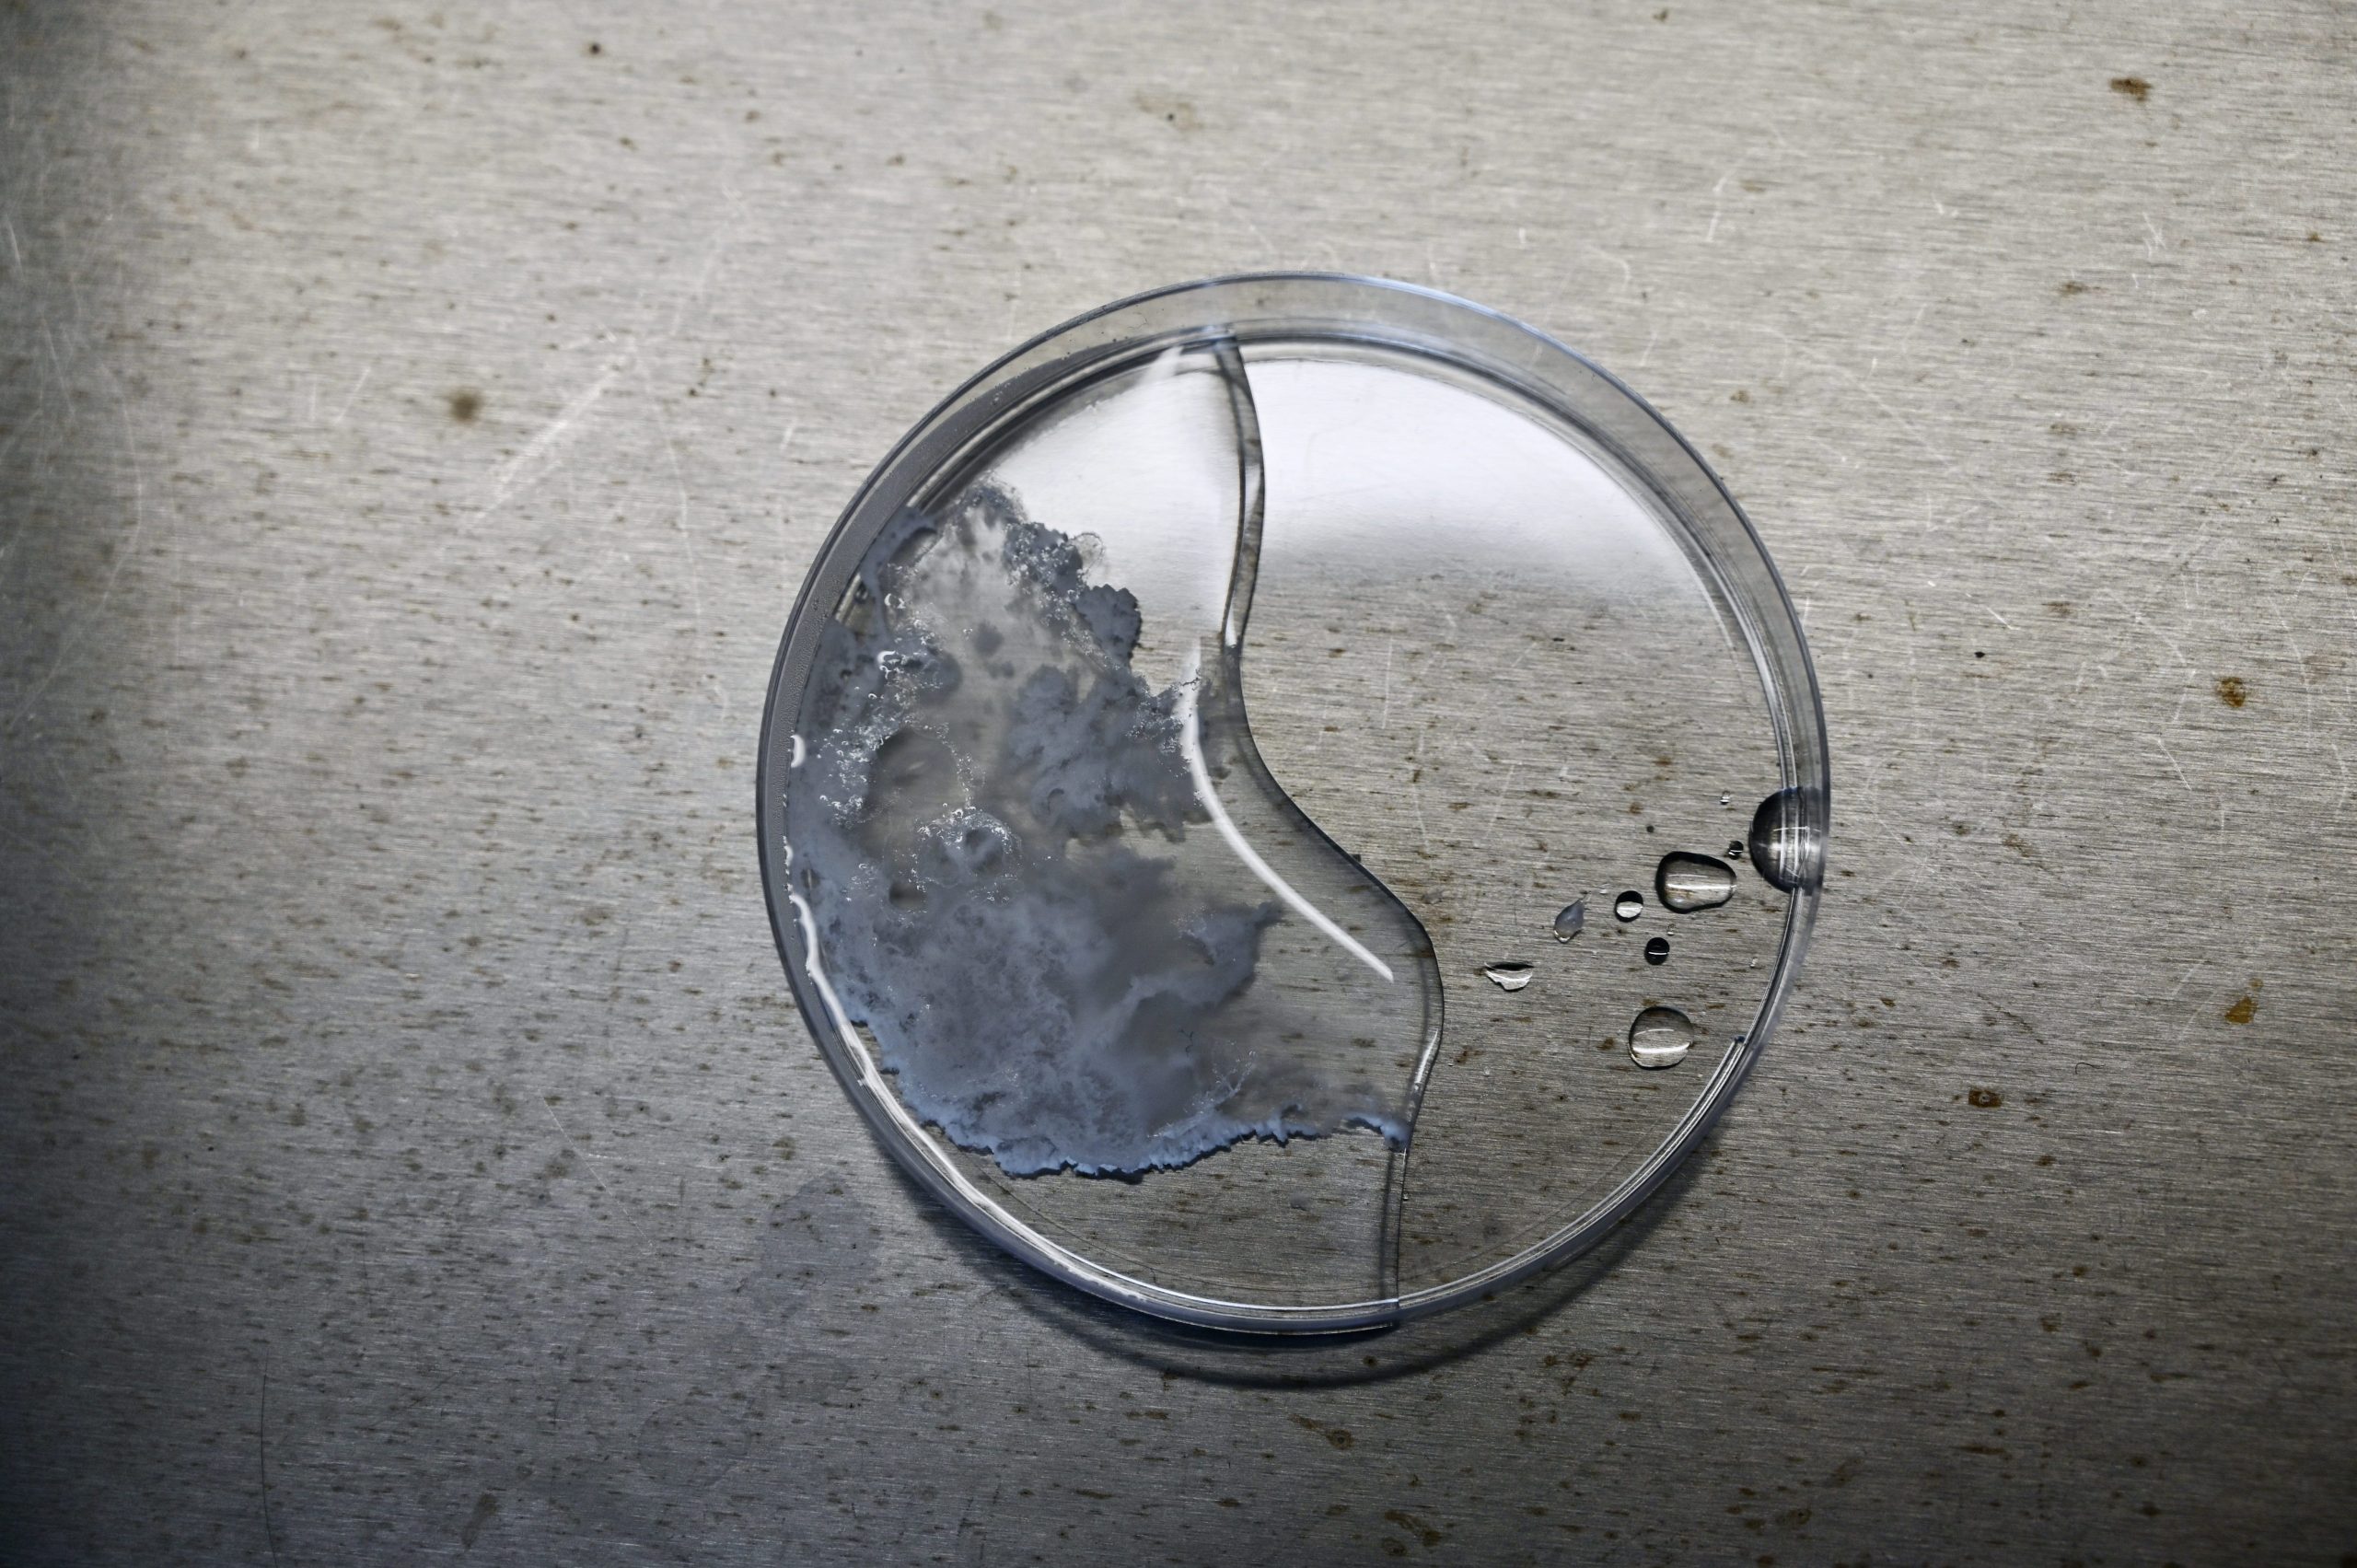

to the moon
multi-part installation: microscope images, graphite on canvas, tidal sand, soil probe, mining slag, synthetic mineral, oxygen pipes, 2021
The historic genre of Moon travels—whether told in fictional or documentary form—has long allowed for the questioning of existing orders and the development of counter-designs. In contrast, current lunar missions mostly evoke extractivist visions of the future, overlooking both the already proven effects on Earth and the potential impacts on lunar nature.
From a chemical perspective, nearly all of the mineral deposits on the Moon that are of interest to humans can also be found on Earth and are already being utilized in industrial processes. Building on this analogy, Wenzel explores the geological aftermath of local mining, incorporating it into a lunar journey that portrays the devastation of a landscape, the loss of a companion, and the disruption of a vision.
The project was funded by the Graduate Grant from the State of Saxony-Anhalt.
installation photos by Max Mendez